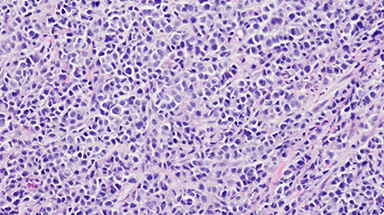
esophageal cancer cell

Areas of Cancer Expertise
No type of cancer should stop you from doing the things you love.
At UPMC Hillman Cancer Center, we provide the expert care you need to fight your cancer and live life to the fullest.
Our team of experts treats all adult cancers, including:
- Adult brain cancer.
- Bladder cancer.
- Blood cancer.
- Breast cancer.
- Head and neck cancer.
- Lung cancer.
- Melanoma.
- Mesothelioma.
- Metastatic colorectal cancer.
- Multiple myeloma.
- Pancreatic cancer.
- Peritoneal carcinomatosis and ovarian cancer.
- Prostate cancer.
- Renal cancer.
- Sarcoma.
- Thyroid cancer.
We also care for those with melanoma, sarcoma, and mixed tumor conditions.
We're here to guide you through prevention, early detection, diagnosis, treatment, and beyond.
As the National Cancer Institute's only comprehensive cancer center in southwest and central Pa., you have world-class care close to home.
UPMC Hillman Cancer Center has more than 70 locations in Pennsylvania, Ohio, Maryland, and western New York.
Search for a Cancer Type or Cancer Topic

AYA Oncology
»The Adolescent and Young Adult (AYA) Oncology Treatment Program meets the unique needs of young people with cancer. Pediatric and adult oncologists provide collaborative, specialized care and the latest treatments.
Learn More
Blood Cancer
»The blood cancer experts at UPMC Hillman Cancer Center care for people who have leukemia, lymphoma, and multiple myeloma. Our multidisciplinary approach gives you access to advanced diagnostic tools and treatments, as well as emotional support.
Learn More
Breast Cancer
»Our Breast Cancer Treatment Program provides personalized care for women and men with breast cancer. We tailor treatments based on your type and stage of breast cancer, including the most advanced therapies with the latest clinical trials.
Learn More
Cancer Immunotherapeutics Center
»UPMC designed the Cancer Immunotherapeutics Center (CIC) to speed the most promising new immunotherapies toward large clinical trials. A diverse team conducts early-phase trials on all aspects of immunotherapy across the spectrum of cancer.
Learn More
Colon, Rectal & GI Cancer
»UPMC Hillman Cancer Center's colorectal and GI cancer team offers a full range of treatments and the latest therapies. We care for the whole person — supporting you through every phase of your battle with cancer.
Learn More
Endocrine & Thyroid Cancer
»At UPMC Hillman Cancer Center, we offer complete and innovative care for endocrine cancer and cancers of the thyroid, parathyroid, pituitary, and adrenal glands. Our endocrine cancer experts review your specific case and tailor a treatment plan to meet your needs.
Learn More
Esophageal Cancer
»UPMC Hillman Cancer Center provides state-of-the-art, evidence-based care to people with esophageal cancer. As one of the largest integrated community networks of cancer specialists in the country, you have access to the highest level of cancer care close to home.
Learn More
Exercise Oncology
»When someone first learns they have cancer, physical activity and exercise may be the last thing on their mind. But research shows that being active can help improve both your physical and mental health.
Learn More
Gynecologic Cancer
»Our Gynecologic Cancer Treatment Program offers comprehensive care for cervical, ovarian, uterine, and other women's reproductive cancers. Our team is by your side to support you throughout all phases of gynecologic cancer treatment and recovery.
Learn More
Head & Neck Cancer
»UPMC Hillman Cancer Center's multi-team approach to treating head and neck cancers provides a complete continuum of care. We offer access to a full range of treatments and the latest clinical trials.
Learn More
Immunologic Monitoring and Cellular Products Laboratory (IMCPL)
»UPMC Hillman Cancer Center's IMCPL is responsible for therapeutic cell product generation (CPL), serial monitoring of immunologic functions (IML) in patients with cancer who are treated with biologic therapies, and banking of blood and tissues for patients on clinical protocols (TPF).
Learn More
Integrative Oncology
»Integrative oncology takes a holistic approach to address cancer symptoms and improve quality of life. Along with traditional cancer treatments, methods may include meditation, yoga, massage, and nutrition.
Learn More
Liver Cancer
»Our Liver Cancer Treatment Program offers a variety of options for managing and treating liver cancer. The experts at UPMC Hillman Cancer Center will tailor a treatment plan based on the type and stage of your liver cancer.
Learn More
Lung Cancer
»The Lung Cancer Treatment Program at UPMC Hillman Cancer Center gives you access to a wide range of experts and treatment options. From state-of-the-art surgical techniques to clinical trials, you'll receive the most comprehensive lung cancer care available.
Learn More
Medical Oncology
»At UPMC Hillman Cancer Center, you'll find a full range of medical cancer treatment options including chemotherapy, immunotherapy, hormone therapy, and targeted therapy. Our medical oncologists will work with you to come up with a care plan that meets your individual needs.
Learn More
Melanoma & Skin Cancer
»The Melanoma and Skin Cancer Treatment Program at UPMC Hillman Cancer Center offers complete diagnostic services, advanced treatments, and the latest clinical trials. Our experts provide personal care and support for all phases of melanoma and non-melanoma skin cancers.
Learn More
Neuro-Oncology Program
»At the Adult Neuro-Oncology Treatment Program, you'll receive world-renowned treatment for brain and spinal cord cancer. The program's team includes neurosurgeons, cancer specialists, and other experts who provide complete cancer care — each step of the way.
Learn More
Oncology Services for Transplant Recipients
»UPMC Hillman Cancer Center offers specialized oncology services for liver transplant recipients who develop cancer.
Learn More
Pancreatic Cancer
»UPMC Hillman Cancer Center's Pancreatic Cancer Treatment Program, we consider more than just the type and stage of cancer. We focus on your wellbeing and tailor treatment to you and your way of life. As one of the highest volume pancreatic cancer centers in the United States, you have access to some of the most advanced therapies and clinical trials.
Learn More
Prostate Cancer
»The care team of the Prostate Cancer Treatment Program provides a full range of diagnostic, treatment, and support services. And — as one of the largest integrated community networks of cancer specialists in the country — you shouldn't have to go far for expert prostate cancer care.
Learn More
Radiation Oncology
»Radiation oncologists at UPMC Hillman Cancer Center offer a full range of advanced radiation treatment services. We use the latest technologies for diagnosing and treating many forms of cancer.
Learn More
Sarcoma
»At the Sarcoma Treatment Program, a variety of cancer experts work together to diagnose and treat all types of bone and soft tissue sarcomas. We'll work with you and your referring doctor to create a customized treatment plan that meets your unique needs.
Learn More
Surgical Oncology
»The surgical oncologists at UPMC Hillman Cancer Center work with you and your referring doctor to decide the best way to treat your type of cancer. As one of the leading cancer surgery programs in the country, we offer some of the most advanced technologies and minimally invasive surgical options.
Learn More
Survivorship Program
»The Survivorship Program at UPMC Hillman Cancer Center recognizes that cancer treatment has a profound effect on a patient’s physical and emotional well-being. Through the Survivorship Program, patients are supported starting at diagnosis.
Learn More
Urologic Cancer
»The Urologic Cancer Treatment Program provides the latest therapies and clinical trials for all types of urologic cancers. Our multidisciplinary team will work with you to develop a treatment plan that's right for you.
Learn More
